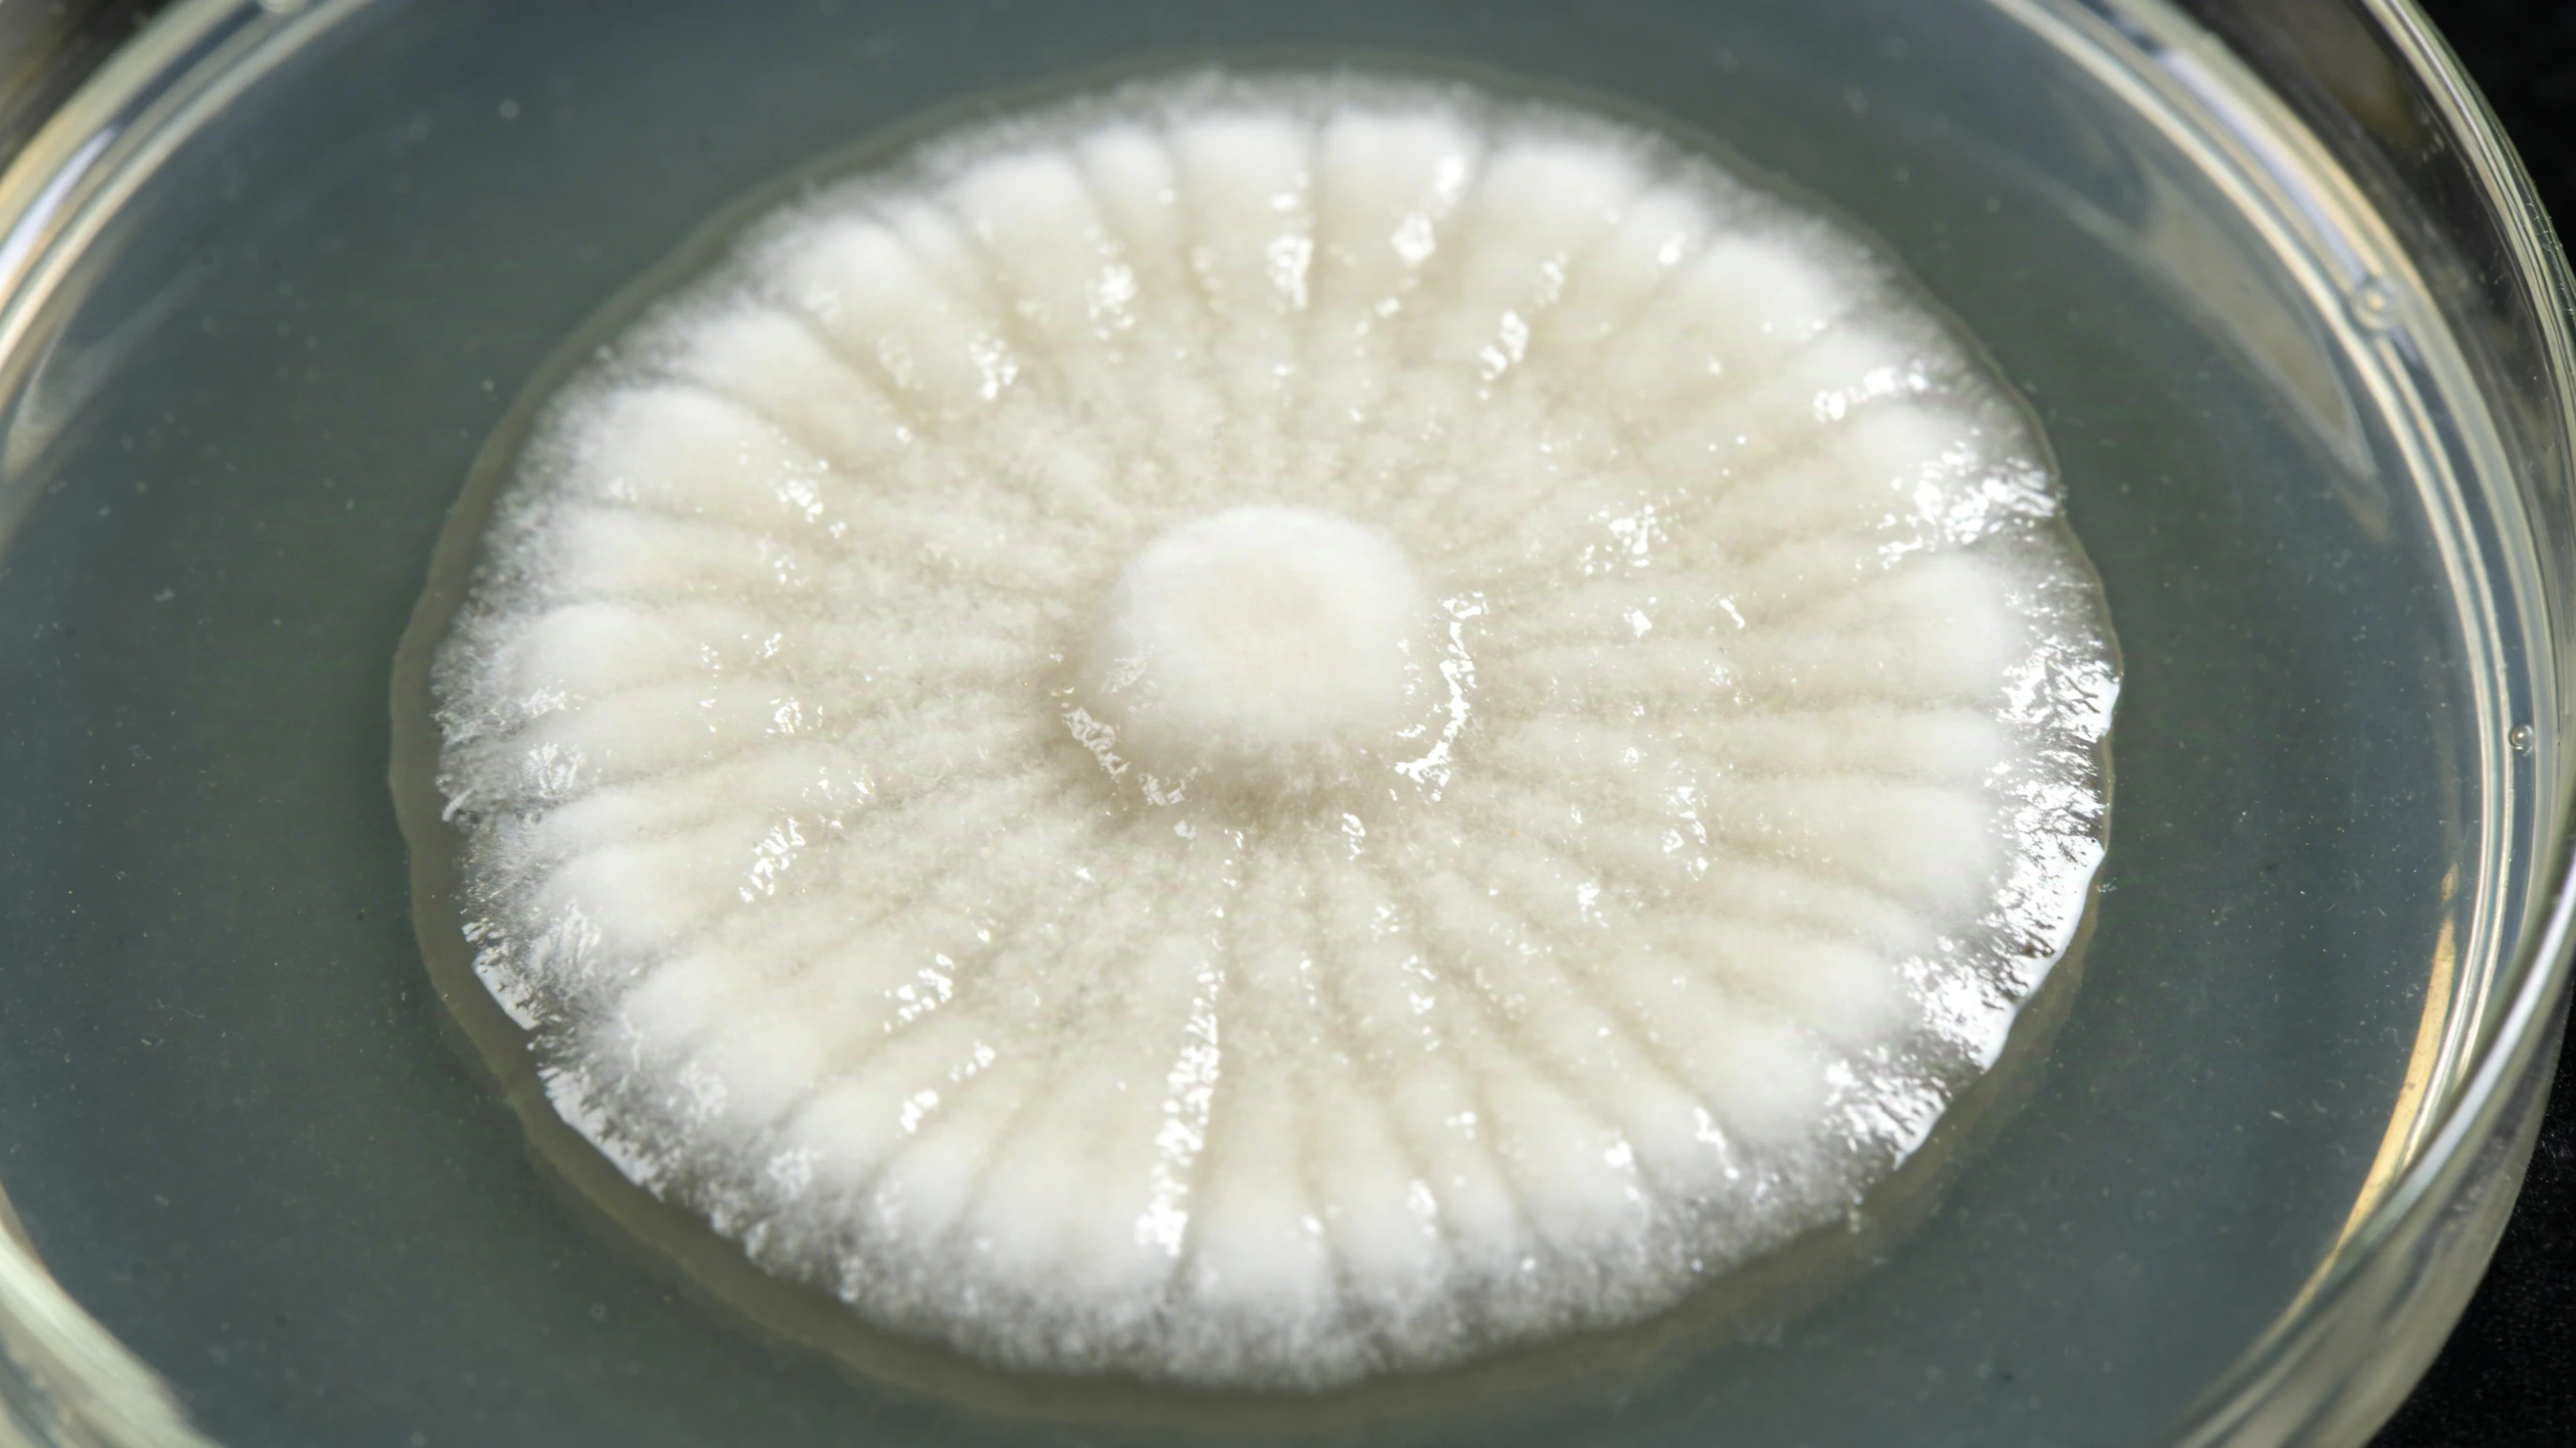

Makes You Naturally Wetter
Eliminates Vag Odor & Taste Issues
Prevents Infections & Balances pH Naturally
Natural Formula That Tastes Good
No Sugar Added
All-Day Confidence Guarantee
*FDA Certified
4-7 Day US Delivery
30 Day Money Back Guarantee
.png?w=2730&h=1535)
-0.png?w=1743&h=1780)








.png?w=2048&h=1933)
loading